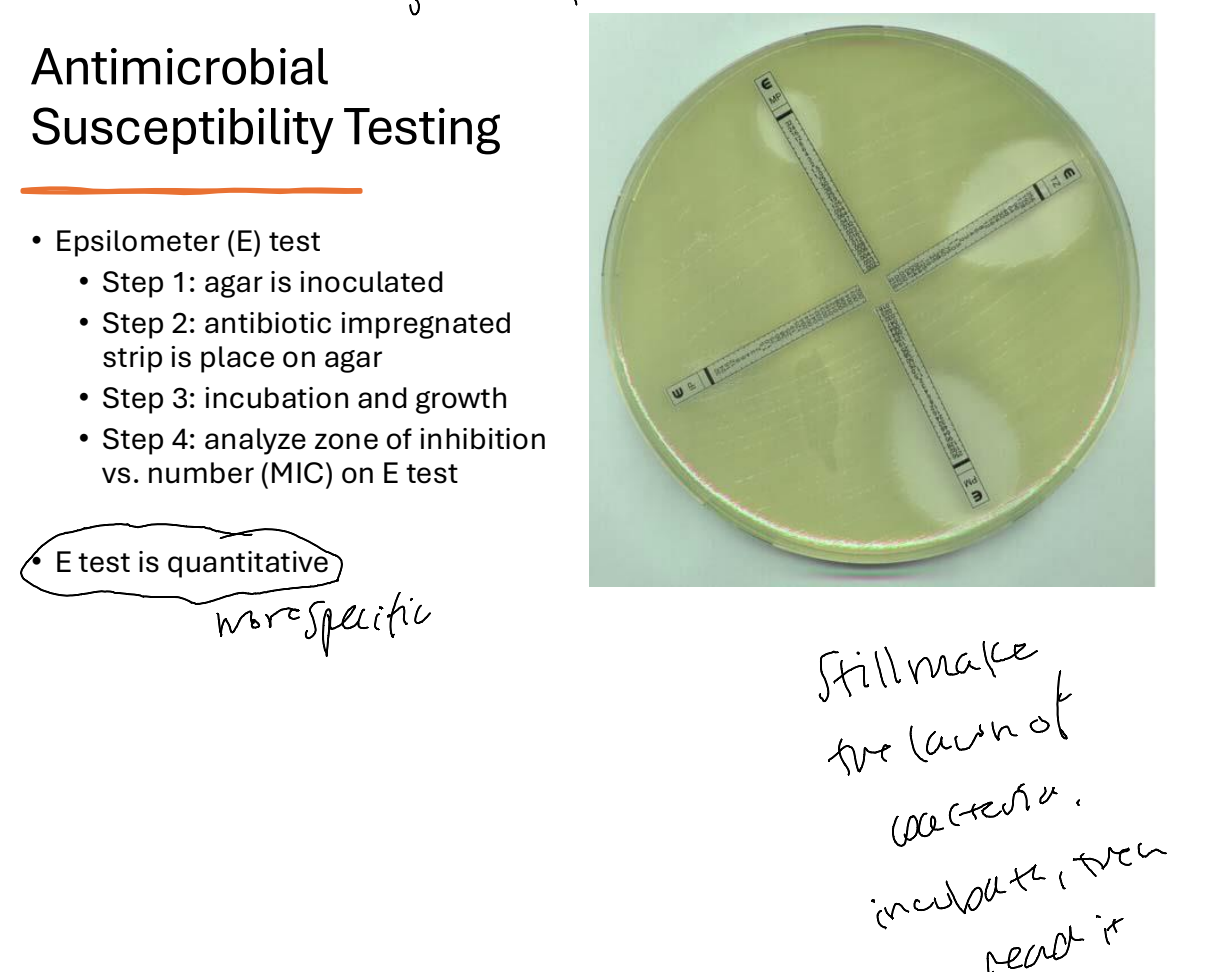

What are two common staining techniques?
Gram stain and acid fast stain
(others include lactophenol cotton blue stain, trichrome stain, and auramine O stain)
What are the 3 different microbial detection methods?
A. Staining
B. Antigen-antibody PCR
C. Cultures
The gram stain is only used for ______.
Bacteria
A gram + bacteria stains ________.
Purple

A gram - bacteria stains ________.
Pink/red

What is the first step in determining the identity of a pathogen and guides the initial antibiotic selection?
The gram stain
What is the information that is obtained from a gram-stain?
Cell wall form (+/-), shape, configuration (pairs/clusters), quantity of bacteria, and other cells in sample like RBCs, WBCs, eosinophils, and more.
What is the goal of an acid-fast stain?
The differentiate bacteria into acid fast group or non-acid fast group. It is mainly used to detect mycobacterium and nocardia species due to the large presence of mycolic acid in the cell wall.
Acid-fast positive cultures will turn the color _____.
Red
T or F: Acid-fast bacterial cells are resistant to decolorization and retain carbol fuchsin stain red color because of their lipoidal cell wall.
True. Acid-fast negative bacteria lack the lipoidal material in the cell wall and are decolorized and counterstained with methylene blue.
What two bacteria are commonly identified with an acid-fast stain?
Mycobacterium and Nocardia species
What are the 3 automated processors that help with organism identification?
Vitek, Microscan, and Sensititre
What is the machine that uses mass spectrometry to identify pathogens?
MALDI-TOF
What are the advantages of the MALDI-TOF over traditional methods for pathogen identification?
Identification can be completed in less than 1 hour
What are three ways in which antimicrobial susceptibility testing can be done?
A. Kirby-Bauer disk diffusion
B. Microbroth Dilution method
C. Epsilometer test
What are the advantages and disadvantages of the Kirby-Bauer disk diffusion test for antimicrobial susceptibility?
It is rapid and inexpensive but it is qualitative and does not provide an MIC

What is the microbroth dilution method?
It is an antimicrobial susceptibility test that is quantitative and gives an MIC.

What is an MIC?
MIC is the minimum inhibitory concentration which is the lowest concentration of antibiotic that inhibits visible growth of a pathogen.
What are the different MIC breakpoint concentrations?
4 or less= susceptible
8= intermediate
16 or more= resistant
What is the epsilometer test?
This is a quantitative antimicrobial susceptibility test that gives the MIC.
What are the overall limitations of antimicrobial susceptibility testing?
It does not take into account patient specific factors, including their immune system, the site of infection, and inoculum size. It also does not detect all resistance mechanisms.
The MIC is a relationship between what two things?
Pathogen and antibiotic
What is the MIC of pseudomonas aeruginosa?
It does not gave an MIC typically.
The relationship between a pathogen’s MIC and an antibiotic fits into the ______________ category.
Pharmacodynamic






